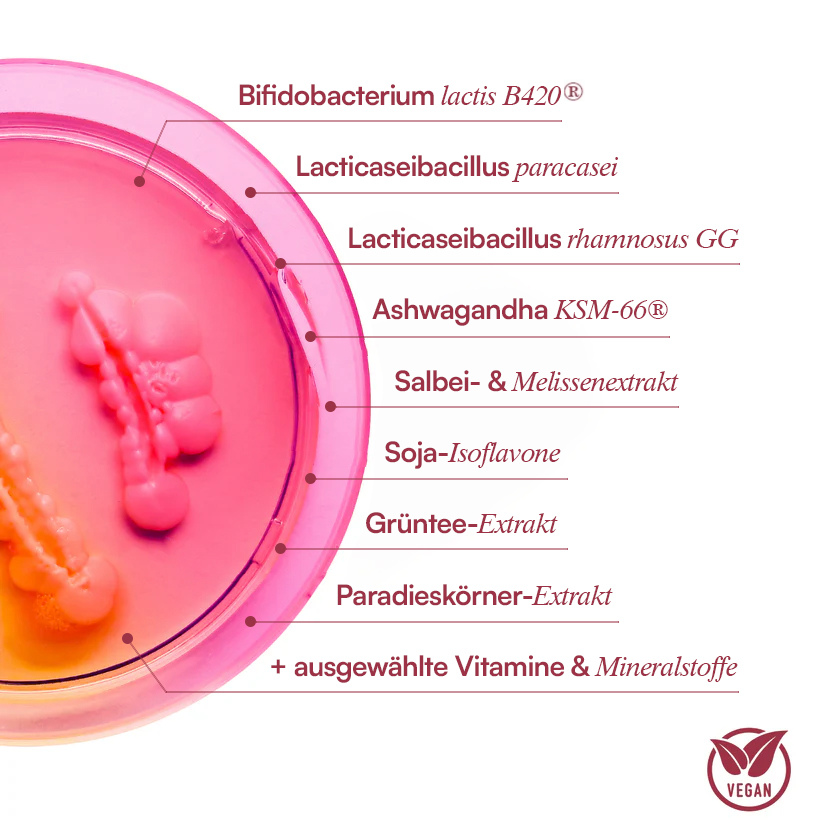

-

Vegan
-

Frei von Gentechnik
-

Hormon frei
-

Versand mit DHL
-

Von Experten entwickelt
-

Klinisch getestet
Die Wissenschaft hinter dem Wechseljahre Complex⁺

Die Biologie
Mit den Wechseljahren sinkt der Östrogenspiegel um bis zu 90 % und auch Progesteron fällt stark ab. Dieses hormonelle Ungleichgewicht verschiebt die Fettverteilung in den Bauchbereich, fördert Wassereinlagerungen, Schlafprobleme und Stimmungsschwankungen. Gleichzeitig blockiert es den Stoffwechsel – Kalorien werden nicht mehr als Energie genutzt, sondern fast automatisch als Fett gespeichert.

Wie der Wechseljahre Complex⁺ hilft
Der Wechseljahre Complex kombiniert klinisch erforschte Probiotika, Pflanzenextrakte und Mikronährstoffe, die den Östrogen- und Progesteronabfall sanft ausgleichen, den blockierten Stoffwechsel wieder aktivieren und das Mikrobiom neu aufbauen. So kann dein Körper Kalorien wieder für Energie nutzen, hormonelles Bauchfett abbauen und typische Wechseljahresbeschwerden wie Schlafstörungen, Stimmungsschwankungen oder Heißhunger lindern.
Excellent
Echte Kunden, Echte Ergebnisse
14 Klinisch geprüfte Inhaltsstoffe, die das hormonelle Gleichgewicht unterstützen
Klicke einfach auf den jeweiligen Inhaltsstoff, um mehr über Wirkung, Studien und Anwendung zu erfahren
-

Bifidobacterium lactis B420®
Unterstützt die Mikrobiom-Balance, fördert Verdauung und Immunsystem und stärkt das Wohlbefinden in den Wechseljahren.
-

Ashwagandha KSM-66®
Hilft, erhöhte Cortisolwerte zu regulieren, unterstützt emotionale Balance und trägt zu besserem Schlaf in den Wechseljahren bei.
-

Salbei Extrakt
Unterstützt die natürliche Temperaturregulation, kann Hitzewallungen reduzieren und fördert inneres Gleichgewicht.
-

Soja Isoflavone
Tragen zur hormonellen Balance bei, unterstützen das Wohlbefinden und helfen, typische Wechseljahresbeschwerden sanfter auszugleichen.
-

Grüntee Extrakt
Fördert die Thermogenese, unterstützt den Energieumsatz und trägt zu einem aktiven Stoffwechsel bei.
-

Chrom
Stabilisiert den Blutzuckerspiegel, reduziert Heißhungerattacken und unterstützt damit eine ausgeglichene Energie im Verlauf der Wechseljahre.
-

Zwei Kapseln einmal täglich
-

Zu jeder Tageszeit
-

Nach einer Mahlzeit

Jetzt risikofrei testen mit unserer 100-Tage-Geld-zurück-Garantie!

Die Wissenschaft, Ärzte und unsere Kunden sind sich einig: Der Wechseljahre Complex wirkt!
Deshalb bieten wir eine 100-tägige, risikofreie Geld-zurück-Garantie an!
Solltest du, aus egal welchem Grund, keine Ergebnisse erzielen oder es dir einfach anders überlegt haben, bekommst du eine volle Rückerstattung.
In anderen Worten: Du zahlst nur, wenn Purefemm dich zu 100 % überzeugt!
100 Tage-Geld-Zurück-Garantie
Erfahre was Experten über uns sagen
Bei Purefemm verwenden wir sorgfältig ausgewählte Inhaltsstoffe, die wissenschaftlich fundiert sind und höchste Reinheit und Wirksamkeit bieten.
Häufig gestellte Fragen
01 Wie lange dauert der Versand und von wo wird versendet?
Alle Produkte werden aus unserem Lager in Polen versendet. Die Lieferzeit setzt sich aus 2 verschiedenen Zeiten zusammen:
1) Bearbeitungszeit:
1-2 Werktage
2) Versandzeit:
Deutschland: 1-3 Werktage
Österreich: 3-5 Werktage
Schweiz: 3-5 Werktage
02 Wie werden die Kapseln eingenommen?
Wir empfehlen 2x Kapseln täglich nach einer Mahlzeit, zu sich zu nehmen. Die Kapseln sollte jeden Tag über mehrere Monate konsumiert werden, um die richtigen Ergebnisse zu sehen.
03 Wie lange kann ich retournieren?
Wir bieten eine risikofreie 100 Tage Geld Zurück Garantie auf alle Bestellungen an. Falls du unzufrieden bist schreib und einfach eine e-mail an info@purefemm.com und lass es uns gut machen.
04 Gibt es Nebenwirkungen?
Zum jetzigen Zeitpunkt sind uns keine Nebenwirkungen bekannt, falls du jedoch jegliche Nebenwirkungen entwickeln solltes konsultiere einen Arzt und stoppe die Einnahme sofort.
05 Wie lange dauert es bis ich Ergebnisse spüre?
Der Körper eines jeden Menschen ist einzigartig, daher können die Ergebnisse variieren.
Während einige Kunden bereits nach 2 Wochen erste Ergebnisse sehen, dauert es in der Regel 8-12 Wochen, bis die Kapseln ihre vollständige Wirkung gezeigt haben.
Deshalb empfehlen wir, das 3-Monatspaket oder 6-Monatspaket auszuprobieren, um in den vollen Genuss der Vorteile zu kommen.
06 Kann ich es mit anderen Nahrungsergänzungsmitteln einnehmen?
Ja, der Wechseljahre Complex⁺ kann in der Regel problemlos mit anderen Nahrungsergänzungsmitteln kombiniert werden, zum Beispiel mit Magnesium, Omega-3 oder zusätzlichen Probiotika.
Die Formel enthält keine synthetischen Hormone und ist so aufgebaut, dass sie körpereigene Prozesse unterstützt, ohne pharmakologisch einzugreifen.
Wenn du verschreibungspflichtige Medikamente einnimmst oder dich in ärztlicher Behandlung befindest, empfehlen wir dir, die Einnahme vorab mit deinem Arzt oder deiner Ärztin abzustimmen.
07 Was genau ist im Wechseljahre Complex⁺ enthalten?
Der Wechseljahre Complex⁺ enthält eine abgestimmte Kombination aus pflanzlichen Adaptogenen, ausgewählten probiotischen Kulturen und Mikronährstoffen.
Dazu gehören unter anderem Ashwagandha KSM-66®, Salbei- und Melissenextrakt zur Unterstützung der hormonellen Balance, probiotische Stämme wie Bifidobacterium lactis B420®, Lacticaseibacillus paracasei und Lacticaseibacillus rhamnosus GG zur Unterstützung des Stoffwechsels sowie Chrom, Vitamin B6, Vitamin D3 und Vitamin K2 für Blutzucker-, Energie- und Stoffwechselprozesse.
08 Enthält es Allergene wie Gluten, Laktose oder Soja?
Der Wechseljahre Complex⁺ ist frei von Gluten und Laktose. Er enthält jedoch Soja, da Soja-Isoflavone Bestandteil der Formel sind.
Wenn du eine Soja-Allergie oder -Unverträglichkeit hast, solltest du vor der Einnahme Rücksprache mit deinem Arzt oder deiner Ärztin halten. Die Kapselhülle besteht aus pflanzlicher HPMC und das Produkt ist insgesamt vegan.
09 Enthält es Hormone?
Nein, der Wechseljahre Complex⁺ enthält keine synthetischen Hormone und ist keine Hormonersatztherapie. Die Inhaltsstoffe unterstützen den Körper dabei, sein hormonelles Gleichgewicht auf natürliche Weise zu regulieren, ohne Hormone zuzuführen oder zu ersetzen.
10 Wie nehme ich die Kapseln ein? Zusammen oder getrennt?
Die empfohlene Tagesdosis beträgt zwei Kapseln. Du kannst beide Kapseln gleichzeitig nach einer Mahlzeit mit ausreichend Wasser einnehmen oder sie aufteilen, zum Beispiel eine morgens und eine abends. Entscheidend ist die tägliche, regelmäßige Einnahme, da der Wechseljahre Complex⁺ auf eine langfristige Unterstützung ausgelegt ist.